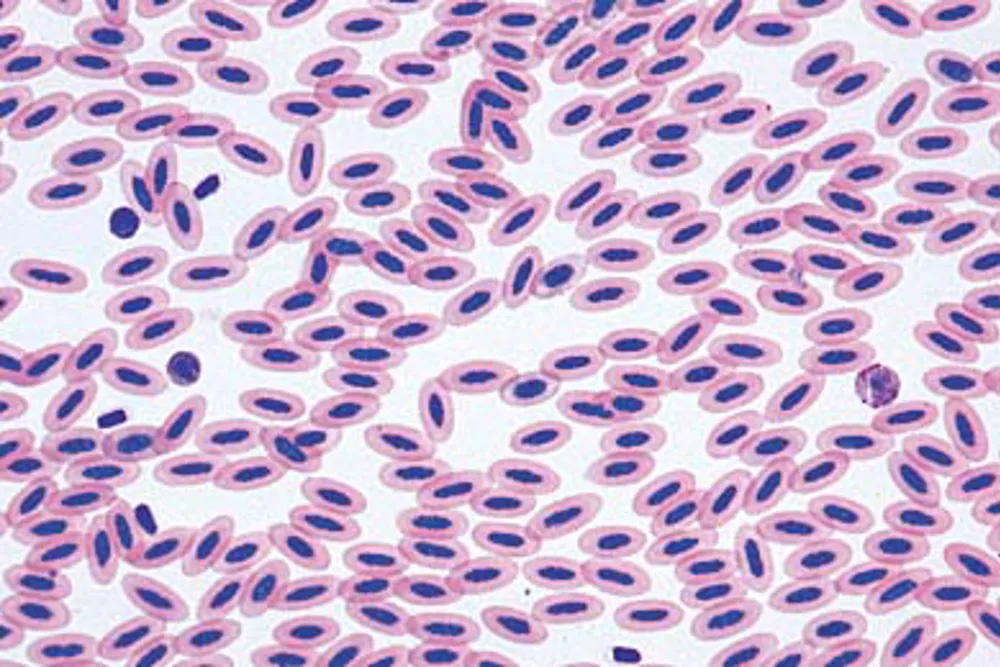

Product Details
Slide chicken, blood smear
Microscopy with chicken blood smear (Gallus domesticus). Johannes Lieder microscopy is of high quality and is manufactured with great care.
Description
This high quality slide provides a detailed visual representation of the blood cells of a chicken. Each slide is unique and may vary slightly in color and shape due to natural variations in biological material. The slides are ideal for showing students that not all animal groups have the same blood appearance as mammals.
Note: Micropreparation is ordered in quantities of 10. Delivery time is approx. 10-12 weeks.
Use of the product
The micropreparation can be used in subjects such as biology and nature/technology. In biology, students can use the preparation to study blood cells and their shape in birds. The preparation can also be included in courses on animal physiology or in comparative studies between human and animal blood cells.